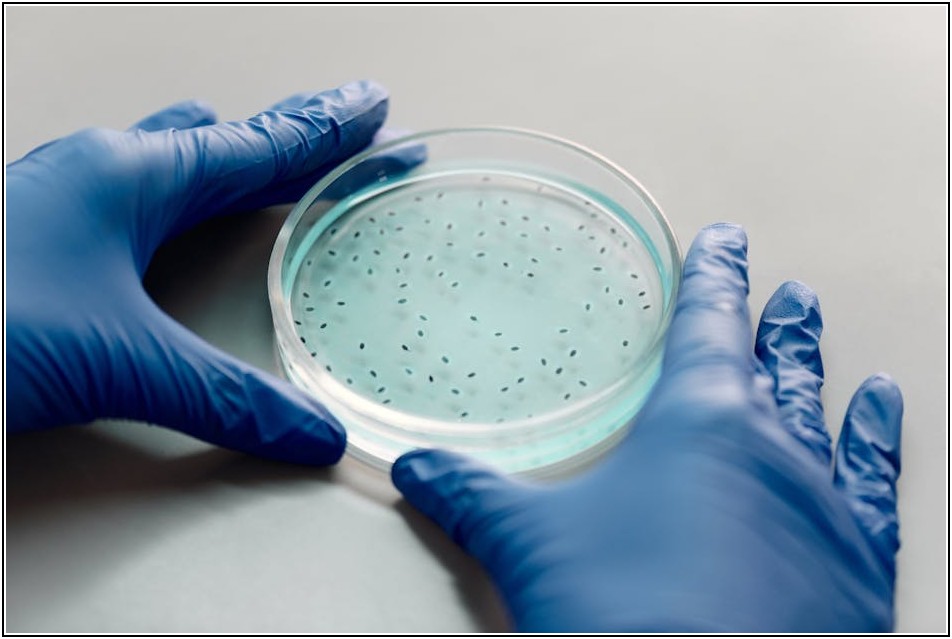
실험 실력 향상의 열쇠, 초자기구 사용법 완전 정복

실험을 하다 보면 때로는 사소한 실수 하나가 전체 결과에 큰 영향을 미치기도 합니다. 특히 유리 재질의 초자기구는 깨지기 쉽고 오염에도 민감하여 더욱 세심한 주의가 필요합니다. 이 글에서는 초자기구를 안전하고 정확하게 사용하는 방법을 집중적으로 다룹니다. 실험실에서 자주 접하는 초자기구들을 올바르게 관리하고 활용하는 노하우를 배우고, 보다 전문적인 실험 환경을 만들어 보세요.
핵심 요약
✅ 정밀한 실험 결과를 위해서는 초자기구의 정확한 사용이 필수입니다.
✅ 세척 및 관리 소홀은 실험 오차의 주된 원인이 됩니다.
✅ 용도에 맞는 초자기구 선택이 중요합니다.
✅ 파손 및 오염에 주의하여 다루어야 합니다.
✅ 실험 안전 절차를 준수해야 합니다.
깨끗함이 곧 신뢰, 초자기구 세척과 관리의 중요성
실험의 세계에서 ‘정확성’과 ‘신뢰성’은 무엇과도 바꿀 수 없는 가치입니다. 그리고 이러한 가치를 지탱하는 가장 기본적인 요소 중 하나가 바로 깨끗하게 관리된 초자기구입니다. 눈에 보이지 않는 미량의 오염 물질도 실험 결과에 치명적인 영향을 미칠 수 있기 때문에, 우리는 초자기구를 세척하고 관리하는 일에 결코 소홀해서는 안 됩니다.
세척, 실험의 첫 단추
실험에 사용될 모든 초자기구는 사용 전에 반드시 깨끗하게 세척해야 합니다. 잔여물이 남지 않도록 꼼꼼하게 닦고, 충분한 양의 증류수로 여러 번 헹구어내는 것이 중요합니다. 유리 재질의 경우, 세제를 사용한 후에는 더욱 각별한 주의가 필요하며, 세제 잔류물이 없도록 세심하게 헹궈야 합니다. 세척 후에는 건조대에 세워 자연 건조하거나, 건조 오븐을 사용하여 완전히 건조하는 것이 좋습니다.
오염 방지를 위한 올바른 보관
깨끗하게 세척된 초자기구는 올바른 방법으로 보관해야 그 상태를 유지할 수 있습니다. 사용 후에는 즉시 세척하고 건조하여 지정된 보관 장소에 원형 그대로 보관해야 합니다. 먼지나 기타 오염 물질로부터 보호하기 위해 캐비닛에 넣어 보관하는 것이 이상적입니다. 특히 정밀 측정을 위해 사용되는 기구들은 각별한 주의가 필요합니다.
| 항목 | 내용 |
|---|---|
| 세척 전 확인 | 균열, 흠집 등 파손 여부 확인 |
| 세척 방법 | 중성세제 또는 전용 세제 사용, 충분한 헹굼 |
| 건조 방법 | 자연 건조 또는 건조 오븐 사용 |
| 보관 방법 | 완전히 건조 후 지정된 장소에 원형 그대로 보관 |
정밀 측정을 위한 선택, 초자기구의 종류별 활용법
실험실에는 다양한 종류의 초자기구가 존재하며, 각각의 도구는 고유의 목적과 정밀도를 가지고 있습니다. 자신의 실험 목적에 맞는 초자기구를 올바르게 선택하고 활용하는 것은 정확한 실험 결과를 얻는 데 있어 매우 중요한 단계입니다.
용액 측정 및 옮기기: 비커, 플라스크, 메스실린더
비커는 용액을 담거나 섞는 데 주로 사용되지만, 정확한 부피 측정에는 적합하지 않습니다. 플라스크(삼각플라스크, 둥근바닥플라스크 등)는 가열, 반응, 용액 제조 등에 사용되며, 메스실린더는 비교적 정확한 부피 측정이 필요할 때 사용됩니다. 그러나 메스실린더 역시 정밀 측정보다는 대략적인 부피를 재는 데 더 적합합니다.
정확한 부피 측정: 뷰렛과 피펫의 활용
가장 높은 정확도를 요구하는 부피 측정에는 뷰렛과 피펫이 사용됩니다. 뷰렛은 적정 과정에서 액체를 조금씩 흘려보내며 반응량을 정밀하게 조절하고 측정하는 데 탁월합니다. 홀 피펫은 정해진 단일 부피를 매우 정확하게 옮기는 데 사용되며, 마이크로피펫은 마이크로리터 단위의 극소량 액체를 정확하게 옮길 때 활용됩니다. 이 도구들은 사용법을 정확히 숙지해야만 그 성능을 발휘할 수 있습니다.
| 초자기구 | 주요 용도 | 정밀도 |
|---|---|---|
| 비커 | 용액 담기, 섞기 | 낮음 |
| 플라스크 | 가열, 반응, 용액 제조 | 중간 |
| 메스실린더 | 부피 측정 (대략적) | 중간 |
| 뷰렛 | 적정 시 액체 정밀 조절 및 측정 | 높음 |
| 홀 피펫 | 고정 부피 정밀 이송 | 매우 높음 |
안전 제일! 실험 중 초자기구 취급 시 주의사항
실험실에서 안전은 그 무엇과도 타협할 수 없는 최우선 가치입니다. 특히 유리 재질의 초자기구를 다룰 때는 파손으로 인한 사고를 예방하기 위해 각별한 주의가 필요하며, 화학물질을 다룰 때는 개인 보호 장비 착용이 필수적입니다.
유리 초자기구 취급 시 안전 요령
유리 초자기구는 충격에 매우 약하므로, 이동 시에는 반드시 두 손으로 안정적으로 잡아야 합니다. 실험대 위에서도 굴러떨어지지 않도록 주의하고, 사용하지 않을 때는 지정된 위치에 가지런히 놓아야 합니다. 급격한 온도 변화는 유리를 파손시킬 수 있으므로, 뜨거운 용액을 갑자기 차가운 곳에 두거나 그 반대의 경우를 피해야 합니다. 깨진 유리 조각은 매우 위험하므로, 발견 즉시 안전하게 처리해야 합니다.
개인 보호 장비와 위험물 취급
화학물질을 다루는 실험에서는 항상 보안경을 착용하여 눈을 보호해야 합니다. 산, 염기 등 부식성 물질이나 유해 물질을 다룰 때는 반드시 내화학성 장갑을 착용해야 합니다. 가열 중인 실험 장치 근처에서는 긴 머리를 묶고, 헐렁한 옷이나 액세서리는 착용하지 않는 것이 좋습니다. 화학 물질을 옮기거나 사용할 때는 항상 환기가 잘 되는 곳에서 작업하고, 비상 시 대처 요령을 미리 숙지해야 합니다.
| 구분 | 주요 주의사항 |
|---|---|
| 유리 초자기구 | 이동 시 두 손 사용, 안정적인 자세 유지, 급격한 온도 변화 주의, 파손 시 안전 처리 |
| 화학물질 취급 | 보안경, 내화학성 장갑 착용, 환기 필수, 비상 대처 요령 숙지 |
| 가열 실험 | 집게, 안전 장갑 사용, 주변 정리 정돈 |
| 일반 안전 수칙 | 정돈된 작업 환경 유지, 음식물 섭취 금지, 실험복 착용 |
실험의 질을 높이는 작은 습관, 초자기구 관리 노하우
뛰어난 실험 결과는 하루아침에 만들어지지 않습니다. 실험자의 섬세한 관찰력과 꾸준한 노력, 그리고 무엇보다 초자기구를 아끼고 올바르게 관리하는 습관에서 비롯됩니다. 작은 습관 하나하나가 모여 실험의 전체적인 질을 높이는 밑거름이 됩니다.
미세한 오염까지 제거하는 세척 노하우
초자기구를 세척할 때는 일반적인 방법 외에도 실험의 종류에 따라 특별한 방법을 사용할 수 있습니다. 예를 들어, 유기물을 제거하기 위해서는 피라냐 용액(황산과 과산화수소의 혼합물)을 사용하기도 하지만, 이는 매우 위험하므로 반드시 전문가의 지도하에 사용해야 합니다. 일반적인 실험에서는 부드러운 솔을 사용하여 기구 안쪽까지 꼼꼼하게 닦는 것이 중요하며, 눈금이 있는 기구는 눈금 사이의 오염도 주의해야 합니다.
초자기구의 수명 연장과 효율적 사용
초자기구의 수명을 연장하기 위해서는 사용 후 즉시 세척하고, 완전히 건조시킨 후 올바른 방법으로 보관하는 것이 가장 중요합니다. 물리적인 충격이나 과도한 열에 노출되지 않도록 주의해야 하며, 목적에 맞지 않는 용도로 사용하는 것은 도구를 손상시키고 실험 결과의 신뢰도를 떨어뜨릴 수 있습니다. 정기적으로 초자기구의 상태를 점검하고, 파손되거나 변형된 기구는 즉시 교체하는 것이 안전하고 정확한 실험을 위한 필수적인 과정입니다.
| 관리 항목 | 세부 내용 |
|---|---|
| 세척 | 사용 후 즉시, 꼼꼼하게, 충분한 헹굼 |
| 건조 | 완전히 건조, 필요시 건조 오븐 활용 |
| 보관 | 지정된 장소, 원형 그대로, 먼지 차단 |
| 점검 | 정기적인 상태 확인, 파손/변형 시 즉시 교체 |
| 사용 | 용도에 맞는 기구 사용, 무리한 사용 금지 |
자주 묻는 질문(Q&A)
Q1: 초자기구를 세척할 때 일반 세제를 사용해도 되나요?
A1: 실험 종류에 따라 다릅니다. 일반적인 실험에서는 중성세제를 사용할 수 있지만, 특정 분석이나 정밀한 실험에서는 잔류물이 실험에 영향을 미칠 수 있으므로 실험 목적에 맞는 전용 세제나 증류수를 사용해야 합니다. 세척 후에는 반드시 깨끗한 물로 충분히 헹궈내야 합니다.
Q2: 덜 마른 초자기구를 사용하면 실험 결과에 어떤 영향을 미치나요?
A2: 덜 마른 초자기구를 사용하면 측정하고자 하는 용액의 농도가 희석되어 정확한 결과를 얻기 어렵습니다. 특히 용액의 부피나 농도를 정밀하게 측정해야 하는 실험에서는 치명적인 오차를 유발할 수 있습니다.
Q3: 유리 초자기구가 깨졌을 때 어떻게 대처해야 하나요?
A3: 유리 조각은 매우 날카로우므로 즉시 안전 장갑을 착용하고, 빗자루와 쓰레받기를 이용하여 조심스럽게 닦아내야 합니다. 미세한 유리 조각까지 제거하기 위해 젖은 휴지 등을 사용할 수 있으며, 반드시 지정된 폐기물 용기에 담아 버려야 합니다.
Q4: 뷰렛과 피펫은 어떤 차이가 있으며, 주로 어떤 실험에 사용되나요?
A4: 뷰렛은 적정 실험처럼 액체를 정확하게 조금씩 흘려보내며 부피를 측정할 때 사용됩니다. 피펫은 일정한 부피의 액체를 정확하게 옮길 때 사용됩니다. 뷰렛은 용액을 조절하며 반응시키는 데, 피펫은 시료나 시약을 정확한 양만큼 준비하는 데 주로 사용됩니다.
Q5: 실험 중 초자기구가 오염되었을 경우, 어떻게 해야 하나요?
A5: 오염된 초자기구는 즉시 사용을 중단하고, 해당 실험의 오염 가능성을 최소화하는 방법으로 분리하여 세척해야 합니다. 필요하다면 실험 전 과정을 다시 수행하거나, 오염이 심각할 경우 해당 도구를 폐기해야 할 수도 있습니다.